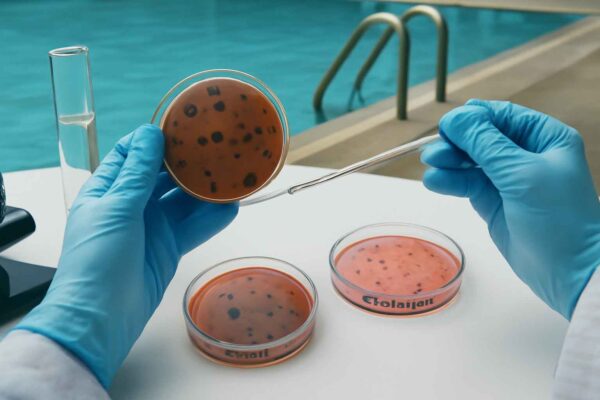
kolam renang

Fikes.umsida.ac.id – Fasilitas umum seperti kolam renang sering menjadi pilihan masyarakat untuk berolahraga sekaligus rekreasi. Namun, di balik kenyamanan tersebut, terdapat persoalan yang sering terabaikan, yakni rendahnya kesadaran terhadap kebersihan dan sanitasi lingkungan.
Riset yang dilakukan oleh dosen Teknologi Laboratorium Medis (TLM) Fakultas Ilmu Kesehatan Universitas Muhammadiyah Sidoarjo (Umsida), Chylen Setiyo Rini SSi MSi bersama tim menemukan bahwa kualitas kebersihan fasilitas umum, khususnya air kolam renang, masih belum memenuhi standar kesehatan .
Kebersihan yang Terlihat Belum Tentu Aman

Banyak masyarakat menilai kebersihan hanya dari tampilan fisik, seperti air yang jernih atau lingkungan yang tampak bersih. Padahal, secara mikrobiologi, kondisi tersebut belum tentu aman.
Penelitian menunjukkan bahwa air kolam renang dapat terkontaminasi bakteri berbahaya seperti Escherichia coli dan Salmonella sp., meskipun secara kasat mata terlihat bersih.
Baca Juga: Gaya Hidup Modern Picu Diabetes dan Gangguan Metabolik, Ini Penjelasannya
Padapenelitian disebutkan juga bahwa sampel air yang diuji menunjukkan adanya pertumbuhan kedua bakteri tersebut.
“Air kolam renang yang tidak diolah dengan baik dapat terkontaminasi mikroorganisme patogen yang berbahaya bagi kesehatan,” dijelaskan dalam penelitian tersebut.
Hal ini menunjukkan bahwa kebersihan fasilitas umum tidak cukup dinilai secara visual, tetapi harus melalui pemeriksaan ilmiah.
Risiko Kesehatan yang Mengintai Pengguna
Rendahnya kualitas sanitasi fasilitas umum dapat berdampak langsung pada kesehatan masyarakat. Bakteri seperti E. coli dan Salmonella diketahui dapat menyebabkan penyakit seperti diare dan demam tinggi.
Kondisi ini tentu menjadi ancaman serius, terutama bagi anak-anak dan kelompok rentan yang sering menggunakan fasilitas umum tanpa menyadari risiko yang ada.
Selain itu, kurangnya kesadaran pengguna juga memperparah kondisi. Kebiasaan seperti tidak menjaga kebersihan diri sebelum dan sesudah menggunakan fasilitas umum dapat mempercepat penyebaran mikroorganisme.
Fenomena ini menunjukkan bahwa masalah kebersihan bukan hanya tanggung jawab pengelola, tetapi juga pengguna fasilitas.
Lihat Juga : Olah Limbah Cangkang Kupang, Mahasiswa TLM Umsida Raih Juara 2 PKP2 PTMA 2025
Perlu Kesadaran dan Pengelolaan yang Lebih Baik
Temuan dalam riset ini menegaskan pentingnya peningkatan kesadaran masyarakat terhadap kebersihan fasilitas umum. Edukasi mengenai pentingnya sanitasi dan perilaku hidup bersih perlu terus dilakukan.
Di sisi lain, pengelola fasilitas juga harus memastikan bahwa sistem pengolahan air dan sanitasi berjalan sesuai standar.
Penggunaan desinfektan seperti klorin harus dilakukan dengan tepat agar efektif membunuh mikroorganisme tanpa menimbulkan dampak negatif.
Baca Juga: Puasa Bisa Memengaruhi Hasil Tes Laboratorium? Ini Penjelasan Dosen TLM Umsida
“Pengelolaan air kolam renang harus memenuhi standar fisika, kimia, dan mikrobiologi agar aman digunakan,” sebagaimana dijelaskan dalam penelitian.
Dengan kombinasi antara kesadaran pengguna dan pengelolaan yang baik, fasilitas umum dapat menjadi tempat yang aman dan sehat bagi masyarakat.
Pada akhirnya, menjaga kebersihan bukan hanya soal kenyamanan, tetapi juga tentang melindungi kesehatan bersama.
Sumber: Riset Chylen Setiyo Rini SSi MSi
Penulis: Elfira Armilia























